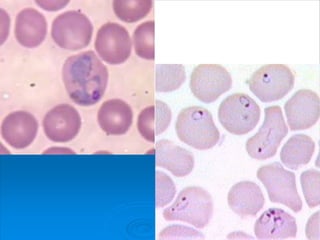
Plasmodium in red blood cell

Protozoans are unicellular eukaryotes that lack cell walls and motility is provided by cilia, flagella, or pseudopodia. They ingest food and can reproduce asexually through binary fission or budding or sexually through conjugation or gamete fusion. Plasmodium, a protozoan parasite, causes the disease malaria in humans. It has a complex life cycle alternating between mosquito and human hosts. In humans it evades the immune system by hiding in the liver and red blood cells, where it consumes hemoglobin and reproduces asexually.